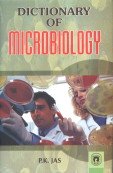
Dictionary of Microbiology

Collection: Products
-
Dictionary of Microbiology
Regular price £26.94 GBPRegular priceUnit price / per -
Dictionary Of Microeconomics
Regular price £21.75 GBPRegular priceUnit price / per -
Dictionary of Military Terms - Hardcover
Regular price £39.23 GBPRegular priceUnit price / per -
Dictionary of Molecular Biology and Biochemistry -Paperback
Regular price £37.48 GBPRegular priceUnit price / per -
Dictionary of Money, Banking and Finance
Regular price £25.98 GBPRegular priceUnit price / per -
Dictionary Of Music
Regular price £32.20 GBPRegular priceUnit price / per -
Dictionary of Music, Dance and Drama
Regular price £39.24 GBPRegular priceUnit price / per -
Dictionary Of Pali Proper Names 2 VOLS. - Hardcover
Regular price £120.97 GBPRegular priceUnit price / per -
Dictionary Of Pali Proper Names 2 VOLS. - Paperback
Regular price £111.78 GBPRegular priceUnit price / per -
Dictionary of Pali-Sanskrit-Hindi-English -Hardcover
Regular price £40.21 GBPRegular priceUnit price / per -
Dictionary of Physical Geography -Hardcover
Regular price £29.96 GBPRegular priceUnit price / per -
DICTIONARY OF PHYSICS, EIGHTH EDITION
Regular price £20.74 GBPRegular priceUnit price / per -
Dictionary of Plant Pathology
Regular price £31.97 GBPRegular priceUnit price / per -
Dictionary of Plant Science
Regular price £21.98 GBPRegular priceUnit price / per -
Dictionary of Plant Sciences
Regular price £24.97 GBPRegular priceUnit price / per -
Dictionary Of Proverbs Of The Sinhalese - HB
Regular price £22.03 GBPRegular priceUnit price / per -
Dictionary Of Proverbs Of The Sinhalese - PB
Regular price £15.21 GBPRegular priceUnit price / per -
Dictionary of Psychology
Regular price £28.99 GBPRegular priceUnit price / per -
Dictionary of Remote Sensing and Geoinformatics -Hardcover
Regular price £32.96 GBPRegular priceUnit price / per -
DICTIONARY OF SCIENCE,SEVENTH EDITION
Regular price £21.95 GBPRegular priceUnit price / per -
Dictionary of Social Work -Hardcover
Regular price £40.02 GBPRegular priceUnit price / per -
DICTIONARY OF SOCIOLOGY (OXFORD QUICK REFERENCE) 4TH EDITION
Regular price £20.84 GBPRegular priceUnit price / per -
Dictionary of Soil Science
Regular price £25.97 GBPRegular priceUnit price / per -
Dictionary of Special Education - Hardcover
Regular price £36.57 GBPRegular priceUnit price / per -
Dictionary of Spiritualism
Regular price £14.00 GBPRegular priceUnit price / per -
Dictionary of Subject Titles
Regular price £25.93 GBPRegular priceUnit price / per -
Dictionary of Teaching and Learning
Regular price £39.38 GBPRegular priceUnit price / per -
Dictionary of Terms Journalism Mass Communication Marketing and Public Relations
Regular price £41.79 GBPRegular priceUnit price / per -
Dictionary of Textile
Regular price £51.38 GBPRegular priceUnit price / per -
Dictionary of Textile Technology
Regular price £68.97 GBPRegular priceUnit price / per -
Dictionary of Tourism
Regular price £21.95 GBPRegular priceUnit price / per -
Dictionary of Travel and Tourism
Regular price £20.75 GBPRegular priceUnit price / per -
Dictionary of Urban and Regional Planning
Regular price £22.97 GBPRegular priceUnit price / per -
Dictionary of Wit and Wisdom
Regular price £20.98 GBPRegular priceUnit price / per -
DICTIONARY OF XML TECHNOLOGIES AND THE SEMANTIC WEB
Regular price £53.98 GBPRegular priceUnit price / per -
Dictionary Telugu-English VOL - 1 , HARDCOVER
Regular price £60.47 GBPRegular priceUnit price / per